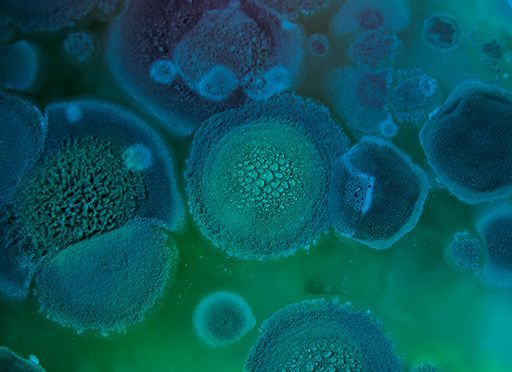

“I Lived All That and I Turned It All Around.”

Dave, can you say a few words about what biohacking is and what inspired you to embark on this journey of improved performance?
Dave Asprey: I spent almost 20 years running an anti-aging nonprofit group, learning from world experts. I could never get anyone under 60 to come to the meetings, even though I was in my late twenties. And I realized that there were all these separate universes of human knowledge that were all looking at different aspects of human performance. There were professional athletes, there were bodybuilders, there were neuroscientists, there was the anti-aging crowd, and regular Western-medicine university researchers. There were even more niche ones, like deep-sea divers looking at oxygen levels. Every field had value when it came to health and performance, but these people weren’t talking to each other. I was looking for something that was accessible and that would unite all of these different aspects into actionable work instead of academic principles. I came up with the word biohacking. And I sat for several weeks and wrote a definition: It’s the art and science of changing the environment around you and inside you, so that you have full control of your own biology.
That sums it up pretty well.
This allows people to say, “You know what I want today? I want to have enough energy to have a two-hour commute home and still be present for my kids.” It’s the same desire that drives the bodybuilder who says, “I want to get strong.” So, different goals, but the same idea: “I’m going to find tools that make the system do what I want, instead of just wondering why it does what it does.” Biohacking is all about practical, actionable ways to make yourself stronger, no matter what your goals are. It became a new word in the English language in 2018. Merriam-Webster’s added it. And my name is actually in the definition, which is pretty cool.
That’s great. Now it’s official.
Yes. So, it’s a movement with millions of people around the globe and almost every country. It’s awesome.
You really did pull all these different threads together and make anti-aging more accessible to everybody.
It has to be tied into the motivations that people actually have. When people are young, they don’t care about life extension, they care about finding a partner and building their career. No one wakes up in the morning and says, “I want to be young today,” unless they’re feeling old. And no one wakes up in the morning and says, “I want to be healthy,” unless they’re feeling sick. We were using the wrong language. What people really want to do is feel really good and have enough energy to do whatever they want today. And to look the way they want to look and feel the way they want to feel. Everyone wants to look, feel and perform at their best. That was the language that I consciously chose.

That makes sense. Let me ask you how you set and monitor your goals? How do you monitor your vital statistics as you go along?
I’ve been tracking my sleep for 15 years now. I used to sleep with a headband on that did that. In fact, I was CTO of the first health tracker on the wrist that could get your heart rate, the way the Apple watch does today. We sold that company for $100 million. So, I’ve been tracking for a long time. What I use today is called the Oura ring. And the reason I use that is it measures: How efficient was your sleep? Did you get lots of sleep in less time?
What does it tell you?
The data shows very clearly, for example, that healthy people need less sleep in order to be fully rested. When you’re unwell, you need nine hours. But when you’re well, the people who live the longest sleep six and a half hours a night. So, if I wake up feeling great and I’ve had more deep sleep and REM sleep than the average college student, and I’m 48, I’m like, okay, things are working. But it also tracks something called heart rate variability, which is a measure of how well your nervous system recovers.
That sounds great.
I use that as a primary measure. And I have other ways to track my vitals too. One of my companies, called Upgrade Labs, is a recovery facility that uses advanced technology to help people either get cardio or muscle faster than you can in the traditional way. But more importantly, to recover faster than mother nature wants you to, from exercise, or from stress, or from anything else. So, what I do there is use one of the pieces of equipment that measures the electrical performance of my cell membranes. And that gives me a really good picture of whether the sum of my practices is helping the cells in my body make more energy for me to use. It tracks my physical fitness at a cellular level.
That sounds like a very direct measurement. But what exactly does it tell you?
It is. It basically tracks how efficiently your mitochondria produce energy. Your mitochondria are the powerhouses of your cells, and when they’re working well, you feel great. Your cells make lots of energy and you feel good all day. But data shows 48% of people under age 40 have mitochondrial insufficiency and pretty much everyone over age 40, unless they’re on an aggressive anti-aging program, has it. So, for me, I can see it. Is my number consistent or going up, or if it goes down, what did I do that wasn’t working for me? And how do I change it? This is invisible stuff. You generally won’t feel this until you’re at a serious deficit. And interestingly, the system that we use at Upgrade Labs, has the ability to tell you, “Your left leg isn’t performing well, but your right leg is.” Do I have something going on there? Did I injure it? Should I stretch some more? That’s been impactful.
I can imagine.
And then my 40 Years of Zen company is the highest-end neurofeedback company there is. People come and spend five days doing brain upgrades. This morning, actually, I just spent three hours with electrodes on my head, looking at my brain’s performance. If I’m doing something wrong, whether it’s food, sleep, exercise, emotional stress, getting sick, it will be reflected in all of those numbers. And if I’m doing things right, they improve. So right now, my hippocampal volume is in the 87th percentile for my age. In other words, my hippocampus isn’t shrinking the way it’s supposed to when you age. My brain’s response time, and this is automatic response time before you can think, is equal to the average 20-year-old’s. And it declines linearly with age, except mine didn’t. I measure my arterial flexibility, and I have the arterial flexibility of a 24-year-old. Some of what I’m doing seems to work.
Wow. I have so many questions now. Have these years of tracking made you more sensitive to how your body feels too?
Absolutely. It’s really interesting because most people wake up in the morning and they go, “Today’s the day,” right? And sometimes you wake up and you’re like, “Today I feel sort of hungover,” and you shake it off and have a cup of coffee, whatever.
But eventually, when you start tracking stuff, you realize there’s always a reason. So, if I wake up and I’m feeling groggy, it’s my fault. I did something, right? It’s not just magic and it’s not random. And then the question is, what did I do?
And I have this constant awareness of like: How’s my focus right now? How’s my energy? Over the course of 20 years it’s enabled me to learn a lot about biology. In my most recent book, Fast This Way, I explain there’s five classes of food toxins that impact your performance and your cravings. If you can intermittent fast and you don’t care about food, that was a good day. And if you’re trying to intermittent fast and you’re just constantly food obsessed, it’s not random. What did you have for dinner last night? So, you can tease out principles that work for just about everyone, but it’s not always the same. I’m blessed because before I was 30, I had most of the diseases of aging: arthritis when I was 14, prediabetes, high risk of stroke and heart attack on lab panels, massive cognitive dysfunction, chronic fatigue syndrome, gut issues, antibiotics for 15 years for strep throat.
That must have been quite a journey to health.
I lived all that and I turned it all around. That also probably made me a bit of a canary. I can say, well, why is this happening? And then I can do the science and realize, wait a minute, this is a really big thing. And there’s a researcher somewhere who knows about this, but no one listens to him. And then I can use the microphone that I’ve built with Bulletproof Radio – it has a couple hundred million downloads – and I can say, “Guys, maybe we should all pay attention to this.” And that’s why, collectively, people have lost over a million pounds in weight on the Bulletproof Diet. It’s changed a lot in people’s lives.

I do not doubt it. I think Bulletproof coffee is a fantastic hack to get you going in the morning. Let me ask you for a few of your top-line hacks that any one can use or integrate into their life.
Sure. One of the easiest things people can do, probably first and foremost, is learn how to intermittent fast. And the reason this is so important is then you spend less time, less energy, and less money on breakfast than you do today. So, you immediately get a return because you haven’t used your morning. And when you do it with the stuff that I teach, you’re not hungry all morning and you’re more focused. So, you’ve got more energy that morning and you save time. And then over a period of time, over a couple of years, suddenly you’re not insulin resistant and you’re not one of the 88% of people who are metabolically unfit.
Can you say more about intermittent fasting?
Intermittent fasting is accessible to everyone, and it’s very impactful biologically, and it gives you more energy. You’re not hangry and hypogly-bitchy and all of those things. As long as you maybe start out using the fasting hacks so that you can become metabolically flexible without sitting there and trying to focus on a meeting with two kids bouncing around the house who should be in school. And also, you’re hangry. Like, that’s not going to end well. So painless fasting would be number one.
Before we move on, can I just ask you to explain what Bulletproof coffee is and how that fits into intermittent fasting?
Ten years ago, I released the Bulletproof Diet online and published the book in 2014. It is the first major book that talked about intermittent fasting as an important part of a lifestyle. And I guided people to use Bulletproof coffee during an intermittent fast. In my newest book Fast This Way, I go a little bit more into the science on that. It turns out there’s three things you can do during an intermittent fast that turn off hunger, turn up energy, but don’t break the fast. One of them is a cup of black mold-free coffee. And the mold-free matters because a lot of coffee makes you want to punch people, if you drink too much of it. It’s because of toxins in the coffee.
And Bulletproof coffee?
It’s mold-free black coffee blended with a little bit of grass-fed butter and some Brain Octane C8 MCT oil. What that does is, it raises ketones in the body as if you’ve been fasting for two days, even though it’s just right after you drink it. A small rise in ketones turns off a hunger hormone called Grehlin, and it turns on a fullness hormone called CCK. All of a sudden now, you’re not feeling the fast, but you’re still getting the metabolic benefits and the cognitive benefits. The third thing is prebiotic fiber. Prebiotic fiber doesn’t raise your blood sugar. It doesn’t break the fast, but it feeds your good gut bacteria. And it creates feelings of fullness, and it’s associated with living longer anyway. So, people really benefit from doing any one or all of those three things during an intermittent fast. And those are some of the fasting hacks in Fast This Way.
Cool. Thank you. Did you want to throw in another non-fast related hack?
Sure. Another really important thing is, we spend approximately a third of our lives asleep. People like to say, “Oh, you need to sleep eight hours a night”. They never talk about how good the sleep needs to be. I would rather get six hours of awesome sleep than eight hours of bad sleep.
But most people don’t even know how well they sleep…
Right. So, if you focus on changing your sleep environment and your sleep habits, so that you get more return on the time you spend when you’re asleep, you’ll probably end up wanting to sleep less. But more importantly, you’ll wake up feeling great instead of waking up feeling average. The best things for that are: Move your dinner time a little bit earlier, that helps a lot. And for at least three hours before bed don’t eat anything, or ideally, four or five hours.

And surprisingly, you really do sleep better! And also, if I may add, you need to make your room into a sleep cave. This means you have actual blackout curtains that allow no light to come in. This is based on lots of studies. For instance, the amount of light that comes around your curtain from streetlights is enough to increase depression symptoms by 69% in the study of 800 people.
Oh wow. I didn’t know that. What about other lights in the room?
Unplug or tape over every blinky light in your room – leave no light whatsoever – and that will totally change things. Dim the lights in your house because light is the largest signal to your brain and your central timing system about whether it’s time to sleep or time to be awake. So, if your bathroom lights are bright and you go to brush your teeth, you might go to sleep, but you won’t get good sleep for a long time. What I do is, I dim all the lights in the house. Red lights at night work fine. But if you have your normal lights on at full brightness, it will mess with your sleep a lot more than most people think.
I’m sure people will appreciate getting a better night’s sleep, thank you for that. So, you’re really pulling together all these different disciplines and exploring the leading edges of human potential very comprehensively. I want to know what’s blowing your mind these days? What are some of the more surprising things you’re learning about and some of the more surprising hacks you’ve developed as a result of your research?
Well, what’s blowing my mind is that, 20 years ago, if a university professor said they were pursuing anti-aging, their job was at risk. Literally, they would be laughed out of academia. And today I’ve become friends with, and have interviewed, dozens of people from the biggest institutions who are unpacking aging and they’re willing to stand up and say, “We can reverse biological aging in cells.” I’ve had likely more stem cells than any other human. I see a guy called Dr. Harry Adelson. He has been on my show a few times, in Park City, and we’ve done stem cells in every joint of my body, inside my cerebrospinal fluid, along the inside of my spinal cord, reproductive organs, face, hair, everything. So, stem cells, and just the fact that now we understand these aging pathways. It’s not just a couple of people doing it; it’s thousands of people across the globe. And what’s coming in the next five years is unprecedented in human history. We really are getting the proverbial fountain of youth.
The science is truly mind-blowing.
We know there are seven major “pillars of aging” [“shrinking tissues, mitochondrial mutations, zombie cells, cellular straitjackets, extracellular junk, telomere shortening,” as described in Asprey’s book Superhuman] and all of those now have medical, lifestyle, pharmaceutical, or other types of hacks. So, we are looking at a world where we are going to have a substantial portion of the population who are 100 plus years old and feeling completely normal – moving around with ease and on their own, not in retirement homes. Where we have the wisdom of being old and the energy of being young. And this is actually necessary for us to fix some of the problems in the world. Because studies show that people have a substantial improvement in happiness after 60 because they finally did the work to figure out that it doesn’t really matter what the bullies did in seventh grade. They get over their stuff.
That’s funny.
But then, that’s right when their memory starts to go and they start being tired and then they’re at the doctor’s all the time. It’s a shame. You start to figure life out, and then your body begins to fail you.
We are going to have a time in our lives where we have a lot of people who have wisdom and energy combined to give back to their community and it’s going to make the world a really richer place. We are seeing a return to having our village elders and it’s going to be awesome.
That’s incredibly positive. I love hearing that. And you’re right. We certainly need the energy to tackle some the problems that we’ve got in the world.
Think about it. If you were 20 and you knew that you were going to be here for 200 years, would you throw the plastic in the ocean knowing that you would eat it 100 years from now?

Right, good point…You’ve developed a heck of a brand, Bulletproof, that really feels like it’s seamlessly integrated into your life and your life’s work, which is admirable. You mentioned another one of your companies, 40 Years of Zen, which is focused on neurofeedback to improve brain power. People don’t normally think a lot about brainwaves, except maybe those looking into meditation. Can you speak a little about the role that brainwaves play in human health in general?
Brainwaves are fundamentally important to how we show up in the world. And we’ve got something like 10,000, 90-minute sessions of data from 40 Years of Zen of people doing advanced meditation states, where we’re training brains to be not average. So, normal is an average brain performance state; high-performance is an abnormal state. We’re teaching people to be abnormal in the best possible way. And it’s highlighted a lot, because every day, your body takes 30 pounds of air and some amount of food and it makes electricity. You can allocate that electricity in your brain into the states that you want, into the states that are beneficial for you, including meditation states. People have a lot of capacity in there, that most of them have never tapped into.
And you can do this without spending the time it takes to get good at meditating?
When you take an experienced meditator and you hook them up to an EEG machine on their first day at 40 Years of Zen, you can see that they’ve been meditating, because they’ve reorganized their brainwaves. When you meet someone who’s never meditated and you look at their EEG, you can see their brain is kind of chaotic. Then you can show them over the course of a week how to organize their brainwaves in the same way as someone who has spent decades meditating every day. If you do this, you end up having less energy going into automated fear responses that take a lot of energy, less energy on hunger and less energy on old traumatic experiences, even small ones. Which means more energy for evolving yourself or for serving your community or doing whatever you like to do.

So, do alpha waves kind of pull together different parts of the brain, sort of organizing it? Is that correct?
It’s pretty simplified, alpha waves we know about because they’re the largest brainwave that we could measure a long time ago. So, there’s been a lot of older focus on that.
Okay, so what are you primarily focused on?
In the training that I do and in cutting-edge neuroscience, it’s about having the right alpha at the right time between certain sections of the brain. And it’s to the point where we can performance-tune and say, “Mm-hmm, that’s funny. You actually have plenty of alpha, but this part of the brain isn’t talking to that part of the brain with alpha. So, let’s show the brain that it needs to bridge the gap there.” And another part of the brain may have too much alpha and not enough, say, beta. And so, it comes down to these major brain states: There’s delta, there’s beta, there’s alpha, theta, then there’s gamma. And then you look at those things and you say, OK, which of them at what location in concert with other ones is going to create a specific performance state or a spiritual or a healing state. That’s the cutting edge of neuroscience.
Interesting – so hacking your brainwaves for better performance?
Most neuroscience has been around fixing broken stuff or taking a brand-new thing and saying, well, here’s what 10,000 people’s brains look like, so let’s make yours look like those because that’s normal. The problem is that this takes A students and makes them into C students. The good thing is to take F students and make them into C students, right?
Yes, right.
What’s happening in the world of neuroscience now is that we’re just waking up to the fact of not doing this old alpha-style neurofeedback, which is just an ancient thing. Actually, let’s do a more targeted thing where we’re training multiple states at the same time. For instance, gamma is what advanced meditators have. And we’ve been able to show it in 40 Years of Zen, that you can train gamma, which a lot of people think is impossible. So, we regularly see substantial rises in gamma, which is a very sought-after meditative state, that layer on top of alpha.
Wow. The state that only monks are supposedly able to reach after like, 10,000 hours of practice, is that right?
You’re exactly right. And so, the idea here is, few of us have time and energy and want to go sit in a cave for 20 years doing meditation the way we would in the 13th century. So how do we get the results faster? And the same thing even goes for exercise with Upgrade Labs. Throughout all history, there’s two kinds of exercise: run away from tigers, or towards them if you’re hunting, and pick up rocks. And you go to the gym, that’s still what we do. But it turns out I can – quantitatively from two studies at the University of Colorado – give you more cardiovascular benefits in seven minutes on an exercise bike driven by AI than you can get in 45 minutes of riding all out on a bike.
So just by using data and science, we can save people eight hours a week of exercise and give them better results.
Truly amazing, and amazing science.
And so, if you suddenly are like, wait, I got better sleep in less time, I got better exercise in less time. I now have 12 hours this week and I can use them learning or parenting or with friends. This is about freeing us from things that we thought we had to do. Instead of showing only 8% of people exercise as much as the government says they should – and frankly, the government doesn’t know what they’re talking about anyway; when it comes to health, their track record is terrible – we can do better. My job is to help us figure that out.
I would imagine that with data and AI, the ability to get that feedback and crunch the data is unprecedented. I want to ask you if you have any other thoughts about what’s coming in terms of the future of brain-computer technologies?
Well, there are two mind-sets happening right now. There’s the Elon Musk side of things that says, we should implant things in the brain. I’m a little skeptical of that because I’ve run a medical testing company that looks at how the body rejects implanted materials, and it’s way more complex than most people believe. And secondly, we have a ton of hardware that we don’t use in our brain right now. And, as a computer hacker trained in Silicon Valley, an early cloud computing guy, making full use of your existing hardware before you replace it is just good practice. The signal that comes off of our brain already is so strong and almost not tapped into. What I think we’re going to see is companies like Kernel, which has more than $100 million dollars of funding, look at how the brain works and how to get a signal off of it versus implanting things.
Keinen Channel gefunden.So, at the moment, you don’t have much faith in implants?
I think that the implanting thing is much further away than some people think. And so, the future of this is really, you’re sending huge signals all the time in your movement, in your eye movement, in the changes in small capillaries, as well as the electromagnetic, and all of that can be picked up. And with machine learning and AI, we can sort out what’s you versus what’s background. And when that happens, we’ll be able to see what’s going on and allow you to have full control over that in a much more nuanced way than we do today. And that’s going to happen first, before we really start saying, we’re going to put these things in. I think there’s likely to be some unintended consequences of implants. I’m probably not going to be the first to sign up for those.
What about just using subconscious brain activity to interact with technology?
That’s coming a lot more because as soon as you start doing that, it stops being subconscious. And what you find when you do the kind of neurofeedback work that we’re doing now, is that a massive amount of energy goes into subconscious things that aren’t doing anything useful biologically. They’re basically old systems designed to keep you from being eaten by animals. They actually aren’t helping. So, when you start being able to edit those patterns so that you’re less reactive, all the energy that went into those can go into either healing your tissues or go into thinking about stuff that matters. That’s what’s cutting edge right now. That’s what has me fascinated.
About the Author
Dave Asprey is the Founder and Chairman of Bulletproof. He’s the author of several best-selling books including Head Strong and Game Changers.